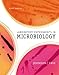
Laboratory Experiments in Microbiology (9th Edition)

Gathering data for you
Our Price Comparison is FREE to use. You are moments away from:
- Buy, Rent or Sell
- New, Used, Rental, eBooks
- Finding the Cheapest Prices
- Saving up to 95%
Check outfacebook
our fan page on
for additional ways to save.
Laboratory Experiments in Microbiology (9th Edition)

- Spiral-bound
- Edition:
- 9
- Publisher:
- Pearson
- Release Date:
- 2009
- ISBN-10:
- 0321560280
- ISBN-13:
- 9780321560285
- List Price:
- $124.00
Cheapest Price Summary |
||||||
|---|---|---|---|---|---|---|
| Store | Condition | Coupons & Deals | Price | Shipping | Total | |
|
Amazon (Marketplace) Used
|
Used | Amazon coupon(s) Details: Get FREE Shipping with a $25+ purchase |
$14.65 as of 3 seconds ago |
$3.99 |
88% off
$18.64Buy Nowclick here!
|
|
-
Store Condition Coupons & Deals Price Shipping Total Amazon
(Marketplace)UsedUsed Amazon coupon(s)
Details: Get FREE Shipping with a $25+ purchase
Restrictions: Spend over $25, see Amazon for details.
Coupon Code: no code needed
$14.65
as of 3 seconds ago$3.99 88% off $18.64Buy Nowclick here!Abebooks
(Marketplace)UsedUsed $25.38
as of 4 seconds agoFREE 80% off $25.38Buy Nowclick here! -
Store Condition Coupons & Deals Price Shipping Total Amazon
(Marketplace)UsedUsed Amazon coupon(s)
Details: Get FREE Shipping with a $25+ purchase
Restrictions: Spend over $25, see Amazon for details.
Coupon Code: no code needed
$14.65
as of 3 seconds ago$3.99 88% off $18.64Buy Nowclick here!Abebooks
(Marketplace)UsedUsed $25.38
as of 4 seconds agoFREE 80% off $25.38Buy Nowclick here!
This book is not available for: New, Semester Rental, 85 Day Rental, 55 Day Rental, eBook, Sell Back
© CheapestTextbooks.com 2001-2026. All rights reserved.

